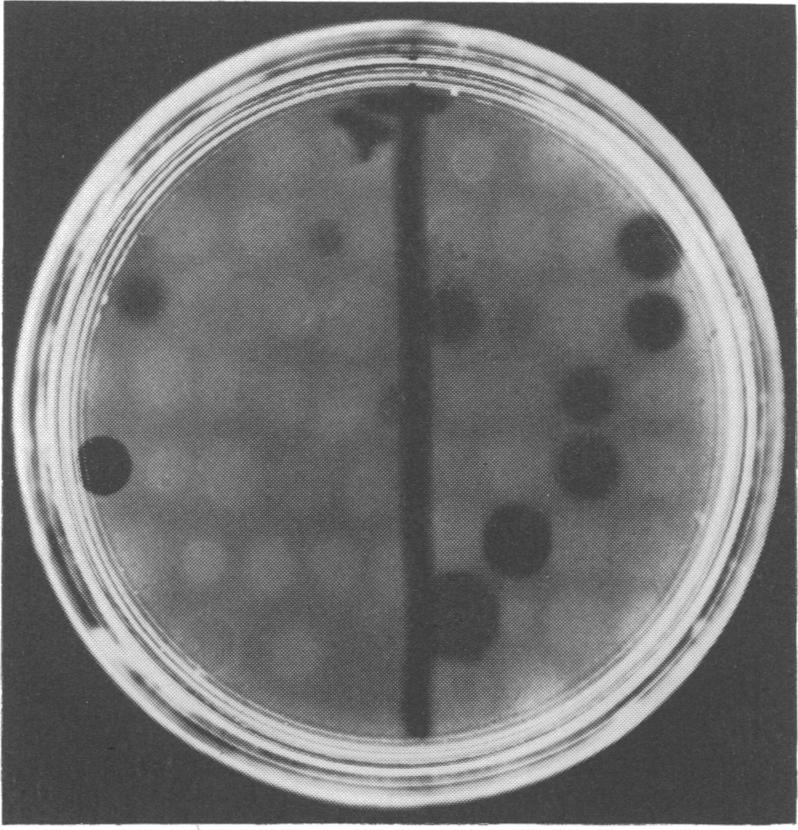

用于快速筛查弓形虫抗体的平板溶血素试验
Plate hemolysin test for the rapid screening of toxoplasma antibodies.
作者信息
Jackson W B, O'Connor G R, Hall J M
出版信息
Appl Microbiol. 1974 May;27(5):896-900. doi: 10.1128/am.27.5.896-900.1974.
A plate hemolysin test was developed to screen serum specimens for the presence of toxoplasma antibodies. When we tested 130 sera by both this test and the standard toxoplasma dye test, we found the plate hemolysin test to be a rapid, sensitive, and economical method for detecting toxoplasma antibodies. In all but one instance it paralleled the dye test. A comparison of the results of testing six sera by the hemolysin, hemagglutination, and dye-test techniques suggested that the hemolytic antibodies were more closely related to hemagglutinating antibodies than to dye-test antibodies. We could not store sheep erythrocytes sensitized with toxoplasma lysate for more than 3 days without altering the sensitivity of the test. Concanavalin A proved to be an effective coupling agent for binding toxoplasma antigens to red-cell membranes, a quality attributed to its affinity for specific polysaccharide-combining sites.
开发了一种平板溶血素试验,用于筛查血清标本中是否存在弓形虫抗体。当我们用该试验和标准弓形虫染色试验对130份血清进行检测时,发现平板溶血素试验是一种检测弓形虫抗体的快速、灵敏且经济的方法。除了一个实例外,在所有情况下它都与染色试验结果相符。对6份血清进行溶血素、血凝和染色试验技术检测结果的比较表明,溶血抗体与血凝抗体的关系比与染色试验抗体的关系更为密切。我们不能将用弓形虫裂解物致敏的绵羊红细胞保存超过3天而不改变试验的敏感性。刀豆球蛋白A被证明是一种有效的偶联剂,可将弓形虫抗原结合到红细胞膜上,这一特性归因于它对特定多糖结合位点的亲和力。